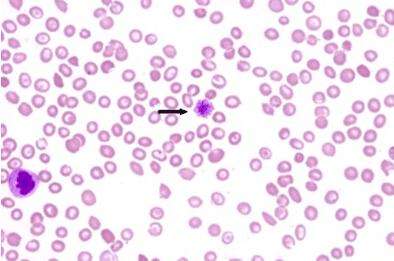

原发性血小板减少能活多久
原发性血小板减少能活多久
400x300 - 23KB - JPEG
原发性血小板减少的症状 需要怎么治疗呢?
原发性血小板减少的症状 需要怎么治疗呢?
394x261 - 15KB - JPEG
 这个是血小板减少导致的?
这个是血小板减少导致的?
500x375 - 12KB - JPEG
 血小板减少会怎样 怎样造成的血小板减少
血小板减少会怎样 怎样造成的血小板减少
650x362 - 24KB - JPEG
 血小板减少的症状
血小板减少的症状
500x375 - 24KB - JPEG
 突发性血小板减少性紫癜能治好吗
突发性血小板减少性紫癜能治好吗
400x300 - 14KB - JPEG
 血小板减少的症状
血小板减少的症状
600x338 - 33KB - JPEG
 血小板减少的早期症状
血小板减少的早期症状
450x340 - 49KB - JPEG
的3个症状,帮你判断是否是血小板减少发病!
640x454 - 51KB - JPEG
 典型的血小板减少紫癜有什么症状特点
典型的血小板减少紫癜有什么症状特点
562x358 - 35KB - JPEG
 血小板减少性紫癜症状
血小板减少性紫癜症状
699x618 - 32KB - JPEG
 血小板减少
血小板减少
720x405 - 38KB - JPEG
 注意 血小板减少性紫癜出现的症状是这些
注意 血小板减少性紫癜出现的症状是这些
293x220 - 15KB - JPEG
 血小板减少的症状
血小板减少的症状
600x338 - 49KB - JPEG
 血小板减少有哪些症状
血小板减少有哪些症状
600x338 - 33KB - JPEG